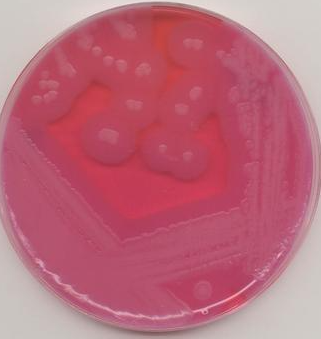
L-鼠李糖发酵管

L-鼠李糖发酵管
L-rhamnose fermentation tube
询价
10支
起订
其他 更新日期:2026-04-21
产品详情:
- 中文名称:
- L-鼠李糖发酵管
- 英文名称:
- L-rhamnose fermentation tube
- 产品类别:
- 培养基
公司简介
“科顺”有科研顺利的良好寓意,公司是集研发、经营、销售为一体的高科技生物公司,主要经营ELISA试剂盒、抗体、生化试剂、标准品/对照品、仪器耗材,公司拥有生命科学领域的高级工程师10名、技术研究员25名及先进的进口仪器,已成为国内一线生命科学领域服务商。
| 成立日期 | (11年) |
| 注册资本 | 100万人民币 |
| 员工人数 | 10-50人 |
| 年营业额 | ¥ 100万-300万 |
| 经营模式 | |
| 主营行业 |
L-鼠李糖发酵管相关厂家报价 更多
-

- L-鼠李糖醇 488-28-8 ARL-鼠李糖醇、EPL-鼠李糖醇、L-鼠李糖醇无水、L-鼠李糖醇有水
- 江苏奥福生物科技有限公司 VIP
- 2026-04-23
- ¥9800
-

- L-(+)-鼠李糖 一水合物
- 上海惠诚生物科技有限公司 VIP
- 2026-04-23
- ¥320
-

- 鼠李糖
- 武汉华玖医药科技有限公司 VIP
- 2026-04-23
- 询价